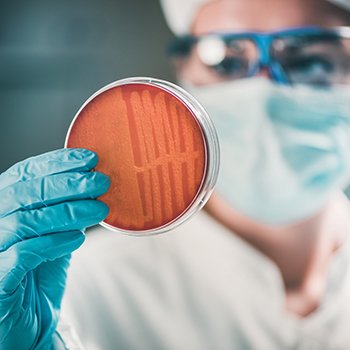

จำแนกเชื้อจุลินทรีย์ได้อย่างทันท่วงทีด้วยเทคนิค MALDI-TOF MALDI-TOF for Rapid Microbial Identification
7849 Views |
จำแนกเชื้อจุลินทรีย์ได้อย่างทันท่วงทีด้วยเทคนิค MALDI-TOF
MALDI-TOF for Rapid Microbial Identification
By: อริยะ ไชยสวัสดิ์
Ariya Chaisawadi
Laboratory Manager
Biopharmaceutical Characterization Laboratory
King Mongkut's University of Technology Thonburi (KMUTT)
ariya.cha@kmutt.ac.th
การจำแนกชนิดเชื้อจุลินทรีย์ (Microbial Identification) เป็นวิธีการวิเคราะห์ทางจุลชีววิทยาประเภทหนึ่งซึ่งเป็นการตรวจสอบคุณภาพของผลิตภัณฑ์อาหาร โดยสามารถจำแนกกลุ่มของเชื้อจุลินทรีย์ได้ถึงระดับจีนัส (Genus) หรือสายพันธุ์ (Species) ซึ่งข้อมูลเหล่านี้จะถูกบันทึกไว้ในฐานข้อมูลของเชื้อแบคทีเรีย (Bacterial Profile) ในบริเวณพื้นที่การผลิตนั้น นอกจากนี้ ยังสามารถระบุถึงแหล่งที่มาของจุลชีพที่ปนเปื้อนในผลิตภัณฑ์ว่ามีการปนเปื้อนมาจากแหล่งใด เช่น สิ่งแวดล้อม กระบวนการผลิต หรือผู้ปฏิบัติงาน อันจะนำไปสู่กระบวนการสืบสวนหาสาเหตุในการปนเปื้อนของเชื้อจุลินทรีย์ต่อไป
การจำแนกเชื้อจุลินทรีย์ด้วยเทคนิค MALDI-TOF
ในปี พ.ศ. 2518 ได้มีการพัฒนาเทคนิคการวัดมวลสาร (Mass Spectrometry; MS) เพื่อนำมาใช้ในการจำแนกจุลชีพ ด้วยการทำให้สารชีวเคมีของจุลชีพที่สนใจแตกตัวกลายเป็นไอออนและทำการวัดมวลของไอออนดังกล่าวเพื่อใช้ในการบ่งชี้ชนิดของเชื้อจุลินทรีย์ อย่างไรก็ตาม วิธีการนี้ก็ยังมีความยุ่งยากในการเตรียมตัวอย่าง และจากการที่ต้องใช้พลังงานสูงซึ่งอาจทำให้โปรตีนของจุลินทรีย์เป้าหมายแตกตัวเสียหาย ซึ่งจะส่งผลต่อการแปรผลและทำให้ผลการทดสอบไม่สม่ำเสมอ จึงเกิดการพัฒนาเทคนิคการวัดมวลดังกล่าวให้มีความแม่นยำ เชื่อถือได้ และง่ายต่อการเตรียมตัวอย่างมากขึ้น จนพัฒนาเป็นเทคโนโลยี Matrix-Assisted Laser Desorption/Ionization-Time of Flight (MALDI-TOF) ในปี พ.ศ. 2539 ซึ่งหลักการที่แตกต่างจากการทดสอบแบบเดิม คือ การบังคับให้แตกตัวเป็นไอออนแบบอ่อน (Soft Ionization) ซึ่งไม่ก่อให้เกิดความเสียหายกับสารอินทรีย์ที่มีโมเลกุลขนาดใหญ่
หลักการของเทคโนโลยี MALDI-TOF แบ่งออกเป็นสองส่วนหลัก ส่วนแรก คือ Matrix-Assisted Laser Desorption/Ionization (MALDI) ซึ่งเป็นการนำสารตัวอย่างไปผสมกับเมทริกซ์เฉพาะในรูปแบบผลึก และเมื่อกระตุ้นผลึกดังกล่าวด้วยแสงเลเซอร์ที่มีความยาวคลื่นเฉพาะจะทำให้สารตัวอย่างในเมทริกซ์แตกตัวเป็นไอออน จากนั้นไอออนดังกล่าวจะถูกเร่งความเร็วด้วยสนามไฟฟ้าและส่งเข้าไปในท่อสุญญากาศ จึงทำให้ไอออนถูกเคลื่อนที่และแยกไปตามความเร็วก่อนที่จะไปชนกับ Detector เพื่อตรวจวัดมวลของไอออนนั้นๆ ซึ่งขั้นตอนนี้จะเป็นการแยกสารด้วยความเร็วในท่อสุญญากาศซึ่งสัมพันธ์กับมวลของไอออน จึงเรียกกระบวนการนี้ว่า Time of Flight (ToF)
Microbial identification using MALDI-TOF technique
Microbial identification is a microbiological analysis method used for food quality inspection. It can identify the genus or species of microorganisms and the data acquired are recorded in the bacterial profile for the specific production area. It can also identify the source of microbial contamination, such as the environment, production processes, or workers. This will lead to the investigation process to find the cause of the microbial contamination.
In 1975, a mass spectrometry (MS) technique was developed to be used in microbial identification. This technique involves ionizing the biochemical substances of the microorganisms of interest and measuring the mass of ions produced in order to identify genus or species of microorganisms. The difficult sample preparation step and significant energy needed to break down microbial proteins in this technique, however, have an impact on the interpretation and inconsistent test findings. The Matrix-Assisted Laser Desorption/Ionization-Time of Flight (MALDI-TOF) technology, which features a more precise, dependable, and simple sample preparation step, was therefore consequently developed from this mass measurement technique in 1996. The principle of this technology is different from conventional testing. It involves soft ionization, which does not cause damage to biological macromolecules.
MALDI-TOF technology consists of two main processes. The first process is Matrix-Assisted Laser Desorption/Ionization (MALDI), which involves mixing the sample with a specific matrix to produce crystals. After the crystals are activated with laser light of a specific wavelength, the sample in the matrix is ionized. In the second process, ions are accelerated by an electric field and transferred into a vacuum tube. Ions are transported and separated at different speeds in this process and before colliding with the detector in order to determine the mass of a given ion. This process is known as Time of Flight (ToF) as it involves separating substances in a vacuum tube at a speed proportional to the mass of the ions.






